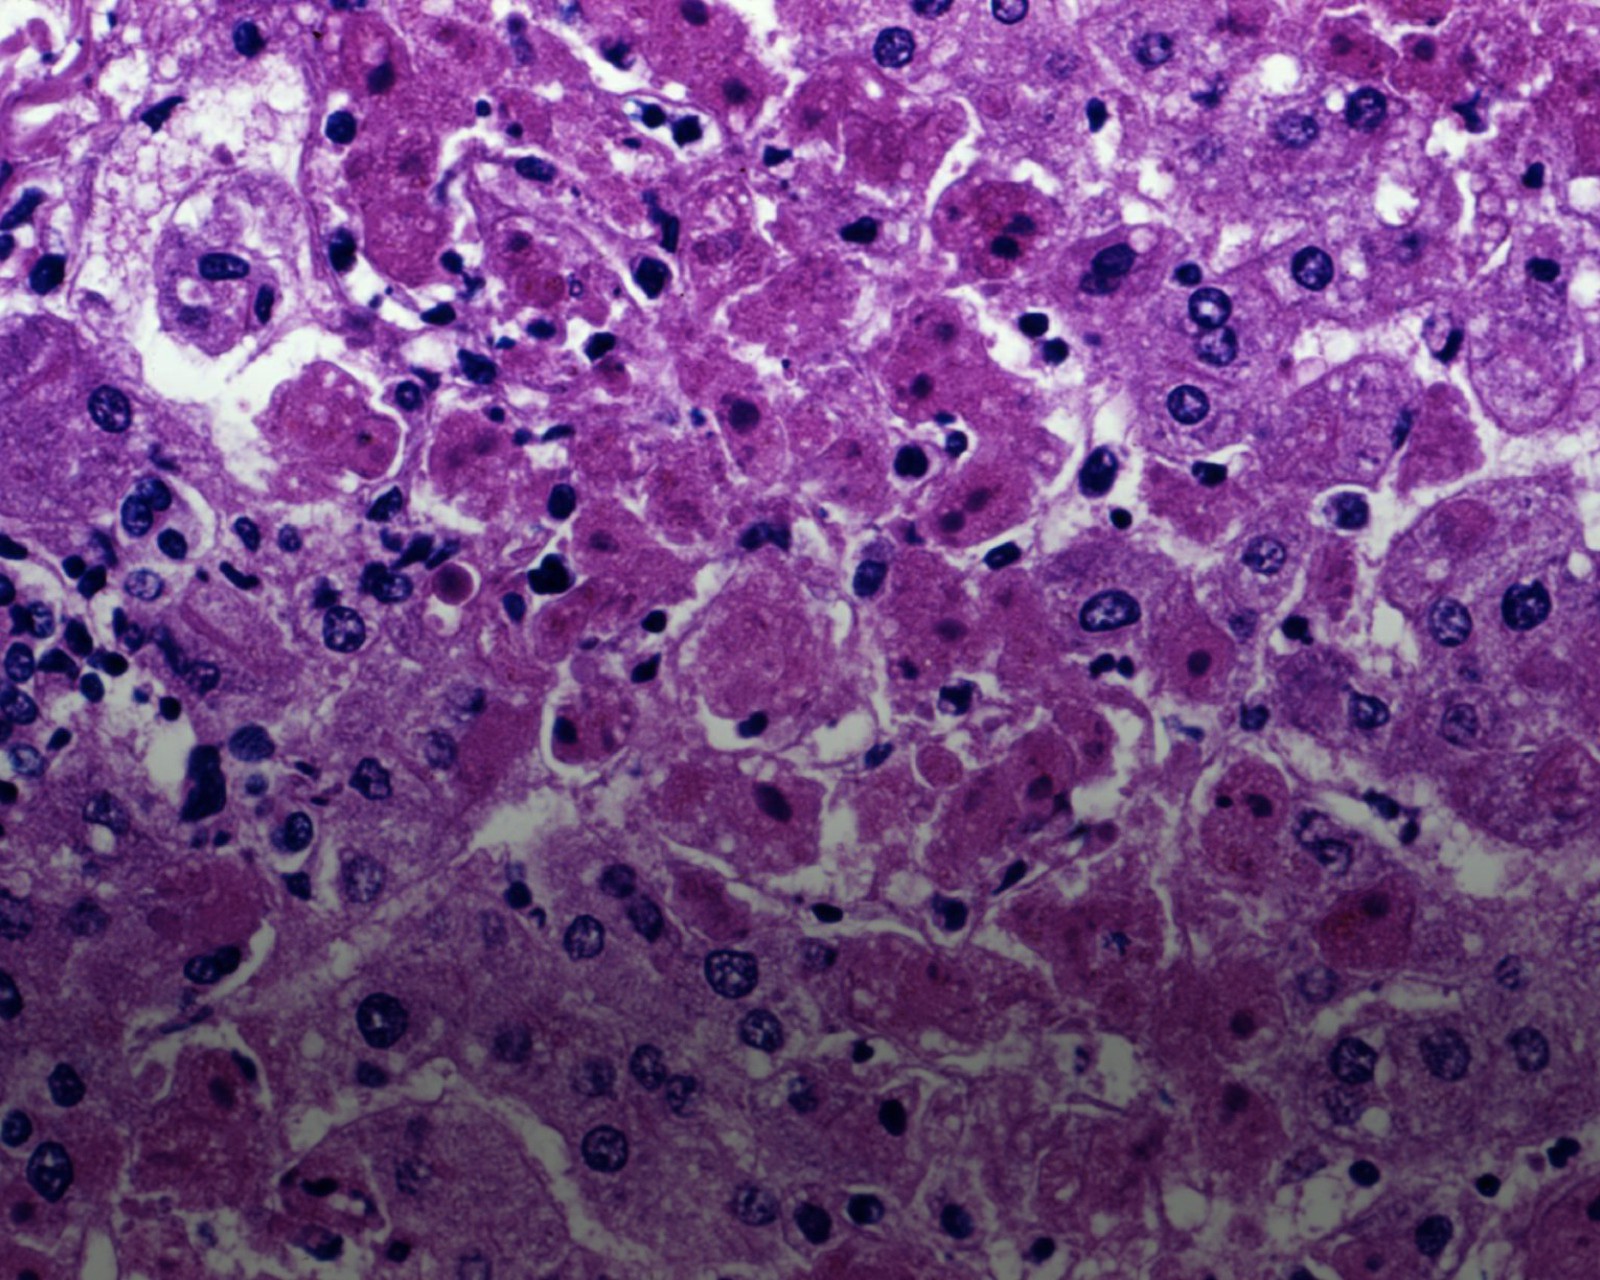
On Livers and Lymph Nodes

Episode 007 - Control Alt Delete Cancer
/Hello and welcome to Episode 7! On this episode, we'll talk with Dr. Haroldo Silva and David Halvorsen of the SENS Research Foundation. They've launched a new crowdfunding campaign designed to attack and stop cancer using a new approach. You'll hear what that approach is, why they think it has a good chance of success, and you can help in the fight.
Read More